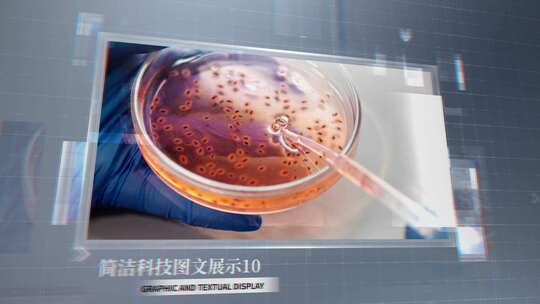
简洁科技企业图文展示

下载后高清无水印
0:00/0:00
- 0.5x
- 0.75x
- 1.0x
- 1.25x
- 1.5x
- 2.0x
素材详情
素材标题:
简洁企业时间线科技图文展示
素材时长:
01:00
音频字体:
仅供参考,无商业授权
最低支持版本:
CC2020

可修改范围:
全部内容均可修改
素材ID:
CsVER2syxlSNgr
更新时间:
2025-12-08 01:39
宽高比:
16:9
素材简介:
中文工程,全是分层内容可随意修改,简单直观,直接替换素材即可使用,包含低版本的AE文件
- 个人授权
企业标准授权
 个人会员专享价12元 AE¥ 15
个人会员专享价12元 AE¥ 15*要求After Effects CC2020及更高版本
- AE个人会员免费
*要求After Effects CC2020及更高版本
加入购物车 立即购买
AE素材用途 (仅限个人使用)

个人作品交流、参赛

个人自媒体平台

个人电商店铺

个人线下用途

企业用途 请购买 企业标准授权
 使用限制
使用限制供稿人上传作品中如含有的国旗国徽等党政图案仅作为整体效果示例展示,对于该类内容请创作人务必遵循法律法规的规定进行使用。